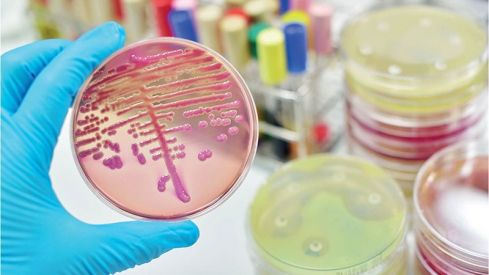

Introducción
Alexander Fleming recibió en 1945 el premio Nobel por el descubrimiento de la penicilina. Y durante su discurso dijo: «Llegará un día en que la penicilina la pueda comprar cualquiera en las tiendas. Entonces existirá el peligro de que un hombre ignorante pueda fácilmente tomar una dosis insuficiente, y que al exponer sus microbios a cantidades no letales del fármaco los haga resistentes». En la actualidad, estas frases premonitorias se están cumpliendo por la aparición de las denominadas «bacterias superresistentes» o «superbacterias».
En 2015, la resistencia bacteriana provocó 25.000 muertes al año en Europa. Las mayores amenazas las constituyen las superbacterias resistentes a antibióticos denominados de «último recurso», como los carbapenámicos o la colistina, y la resistencia adquirida por la bacteria Klebsiella pneumoniae. En Europa, 2 de cada 10 infecciones por esta bacteria ya son resistentes a numerosos grupos de antibióticos.
La principal causa de aparición de las superbacterias son el mal uso y el abuso de antibióticos. Se necesitan técnicas rápidas de diagnóstico y programas de optimización para el uso adecuado de los antibióticos, en el momento, con el paciente, la dosis y la duración adecuada. En España, este programa está en fase de desarrollo e implementación por parte de la Agencia Española de Medicamentos y Productos Sanitarios (AEMPS), en colaboración con la Sociedad Española de Enfermedades Infecciosas y Microbiología Clínica (SEIMC).
Actualmente, además de evitar la aparición y propagación de la resistencia a los antibióticos, el gran reto en términos de salud pública global es el descubrimiento de nuevos fármacos. Si en los próximos años no se desarrollan nuevos antibióticos que sustituyan a los que están perdiendo efectividad, en 2050 morirán en todo el planeta 10 millones de personas al año por infecciones bacterianas.
Los intentos de búsqueda de nuevos antibióticos son numerosos. Actualmente, la investigación en este campo se fundamenta en tres puntos básicos:
- Desarrollar nuevas técnicas de búsqueda de microorganismos productores de antibacterianos.
- Buscar nuevas dianas terapéuticas.
- Desarrollar nuevos antibacterianos.
Nuevas técnicas de búsqueda de microorganismos productores de antibacterianos
La mayoría de las especies productoras de antibióticos se han encontrado en el suelo, pero sólo el 1% de ellas puede cultivarse en condiciones controladas.
En 2015, la revista Nature publicó una nueva técnica que permite cultivar microorganismos que, hasta ahora, no eran cultivables en laboratorio. Se trata de un sistema multicanal de membranas semipermeables, denominado «iChip», que permite aislar y hacer crecer a los microorganismos en su ambiente natural.
Estos investigadores analizaron por este sistema cerca de 10.000 microorganismos diferentes que procedían de muestras de suelo. Su principal descubrimiento fue la bacteria Eleftheria terrae, que tiene actividad antibacteriana frente a Staphylococcus aureus gracias a la producción de teixobactina, de la que hablaremos más adelante.
Otras investigaciones se encaminan a buscar sustancias u organismos productores de antibióticos que no procedan del suelo. Así, en la actualidad existen líneas de investigación centradas en el estudio de las hormigas cortadoras de América del Sur, que tienen una relación simbiótica con el hongo Leucoagaricus gongylophorus. El hongo es alimentado por las hormigas, y las bacterias que crecen en las hormigas ayudan a proteger al hongo de enfermedades. También se está estudiando el hongo Streptomyces leeuwenhoekii, que vive en el desierto de Atacama y en condiciones extremas, y que produce chaxamicinas con propiedades antibióticas (su nombre se debe a su procedencia de la laguna Chaxa), así como algunos tipos de esponjas marinas que pueden ser una fuente potencial para la obtención de antibióticos, puesto que carecen de sistema inmunitario y utilizan las bacterias que viven dentro de ellas para protegerse de enfermedades.
Nuevas dianas farmacológicas
«Biofilms»
Recientemente, se ha comprobado que las bacterias se asocian en colonias y forman una película o biofilm que las hace más resistentes a los antibióticos tradicionales. De esta forma, son hasta 100 veces más resistentes a los antibacterianos que viviendo en solitario.
Este biofilm puede constituir una nueva diana terapéutica para vencer la resistencia bacteriana y potenciar la actividad de los antibióticos tradicionales, a los que las bacterias se habían hecho resistentes.
El equipo de investigación del profesor César de la Fuente-Núñez ha desarrollado un grupo de péptidos, sin actividad antibacteriana, que actúa sólo sobre los componentes del biofilm. Son isómeros D de los péptidos naturales. Una pequeña cantidad de estas moléculas combinada con antibióticos tradicionales ha demostrado ser eficaz frente a bacterias superresistentes como Pseudomonas aeruginosa, Klebsiella pneumoniae, Escherichia coli y Staphylococcus aureus resistente a meticilina.
Uso de «fagos»
Una línea de investigación reciente consiste en el uso de fagos (virus que atacan a las bacterias) para devolver la sensibilidad de las bacterias a los antibióticos a los que se habían hecho resistentes. En este método se utiliza el fago lambda.
En estos estudios, las bacterias resistentes reciben fagos lambda modificados por la técnica de edición genómica denominada CRISPR-Cas, para atacar a los genes de las bacterias responsables de la resistencia. Uno de los fagos integra su genoma en la bacteria y coexiste con ella, y el otro la mata para reproducirse lo máximo posible. El resultado es que la población de bacterias resistentes se vuelve sensible.
Está técnica se está aplicando ya en la esterilización de quirófanos para tratar las superficies expuestas y como componente de jabones utilizados por cirujanos, pero es necesario realizar ensayos clínicos en humanos para saber su potencialidad terapéutica.
Grupo hemobacteriano
En los últimos cien años prevalecía la idea de que los organismos de las bacterias y los de los humanos utilizaban la misma ruta biosintética para sintetizar el grupo hemo. En febrero de 2015, un grupo de investigadores de la Universidad de Georgia puso de manifiesto que la ruta biosintética del grupo hemo de las bacterias grampositivas es diferente. Descubrieron que estas bacterias necesitan una proteína específica, la HemQ, en la parte final de la síntesis del grupo hemo, que es diferente a la proteína HemN que requieren el resto de las bacterias y los organismos superiores para realizar este proceso. Esta investigación constituye una esperanzadora vía metabólica de desarrollo de fármacos antibacterianos mediante la búsqueda de compuestos que actúen sobre esta zona diferenciada de las grampositivas, que además no presentaría toxicidad para el ser humano.
Otras dianas terapéuticas
Existen estudios actuales que plantean el uso de una nueva familia de polímeros con carga positiva y solubles en agua que atraen, mediante interacciones electroestáticas, a las bacterias cuyas membranas celulares están cargadas negativamente. La interacción destruye la membrana y provoca la muerte de la bacteria.
Otra posible nueva diana puede ser la asociación de la ARN polimerasa con sus factores de transcripción o la enzima undecaprenil-pirofosfato-sintasa, que es esencial para la síntesis de la pared bacteriana y, hasta el momento, no existen fármacos inhibidores de ésta.
Teixobactina
En 2015, se publicó el descubrimiento del primer antibiótico en los últimos 26 años: la teixobactina, obtenida a partir de la bacteria Eleftheria terrae.
La teixobactina actúa sobre bacterias grampositivas y, además, no genera resistencia inmediata entre las bacterias supervivientes a su ataque. Esto es debido a que su mecanismo de acción es muy parecido al del antibiótico vancomicina, que ha tardado 30 años en generar resistencia, por lo que no se espera la aparición de resistencia a este nuevo fármaco en unas cuantas décadas.
La teixobactina actúa inhibiendo la síntesis del peptidoglicano de la pared bacteriana, uniéndose a los lípidos que intervienen en su formación. El hecho de que su diana farmacológica sea un lípido, y no una proteína como en muchos otros antibióticos, parece ser la causa de que no desarrolle resistencia inmediata. El fármaco se puede unir a varias dianas, pero ninguna es una proteína. Recientemente, se han sintetizado dos análogos estructurales de teixobactina, y se ha observado que los D-aminoácidos de su estructura son fundamentales para la actividad antibacteriana.
Su espectro de actividad son bacterias resistentes como Clostridium difficile, Mycobacterium tuberculosis y Staphylococcus aureus.
Se han iniciado los ensayos clínicos con teixobactina, pero quedan aún varias fases de investigación para estudiar su posible toxicidad, tolerancia y biodisponibilidad.
Ribocil
La diana farmacológica de este fármaco son los riboswitch. Se trata de fragmentos de ARN con estructura tridimensional, formados cuando el ARN se pliega entre tramos complementarios de su cadena. Los riboswitch tienen funciones propias. Son capaces de reconocer moléculas pequeñas de su entorno (vitaminas, metabolitos, iones, enzimas...), y de este modo pueden regular la transcripción, traducción, corte y empalme y estabilidad del ARN.
Ribocil es un inhibidor selectivo de la síntesis de riboflavina o vitamina B2, molécula esencial en el metabolismo de las bacterias.
El ribocil regula la estructura del ARN, compitiendo eficazmente con la riboflavina por la unión al riboswitch. El fármaco se une específicamente al dominio ARN no codificante (ARNnc), que normalmente está acoplado a flavin-mononucleótido (FMN), cofactor necesario para numerosas reacciones enzimáticas. Al unirse al mismo blanco en el ARNnc, el ribocil «engaña» al riboswitch, de forma que éste responde apagando la producción de riboflavina y privando a las bacterias del metabolito. En diferentes ensayos se ha constatado que las bacterias tratadas con ribocil estaban libres de riboflavina. Este mecanismo de acción no se ha descrito para otros antibacterianos.
Las nuevas alternativas de antibióticos que se unan a estos riboswitch permitirán alterar los niveles de producción de proteínas fundamentales para rutas de biosíntesis de metabolitos esenciales para el microorganismo, y por tanto también para frenar su proliferación.
En los ensayos no se observaron efectos tóxicos en ratones. En ratones infectados con bacterias patógenas, ribocil redujo la concentración bacteriana en más de 1.000 veces, sin efectos tóxicos para los animales.
Lugdunina
Recientemente, investigadores de la Universidad de Tubinga han identificado una bacteria que habita en las fosas nasales de los humanos llamada Staphylococcus lugdunensis, que produce el antibiótico lugdunina, el primer representante de una nueva clase de péptidos antimicrobianos.
Los ensayos con lugdunina han demostrado su capacidad para tratar infecciones cutáneas producidas por Staphylococcus aureus en ratas y frente a una amplia variedad de bacterias grampositivas, y no se ha observado que tenga una gran capacidad de inducir resistencia en S. aureus.
Los investigadores también examinaron muestras nasales de 187 pacientes hospitalizados, y constataron que la colonización por S. aureus era del 5,9% en quienes también eran portadores de S. lugdunensis, frente al 34,7% de quienes no albergaban dicha bacteria. Esto constituiría un indicador de que S. lugdunensis puede proteger frente a S. aureus, al menos en la nariz.
Esta investigación evidencia el potencial de los microorganismos que alberga el cuerpo humano (microbioma) como fuente de agentes antimicrobianos.
Nuevos antituberculosos
Los compuestos denominados «indolcarboxamidas» son activos contra cepas de tuberculosis sensibles y multirresistentes a estos fármacos. Uno de estos compuestos, el NITD304, está en fase preclínica. Actúa bloqueando la MmpL3, una proteína esencial para la supervivencia de Mycobacterium tuberculosis.
Por otra parte, los péptidos y peptidomiméticos han emergido como una importante clase de agentes terapéuticos antituberculosos.
Asociación de antibacterianos clásicos
La progresiva pérdida de eficacia de los antibióticos clásicos ha llamado a recuperar los antiguos. Un estudio dirigido por el Dr. Jordi Vila muestra que la asociación de una cefalosporina (ceftazidina) con un inhibidor de las beta-lactamasas (avibactam) es eficaz frente a bacterias multirresistentes.
Por otra parte, en 2013 un grupo de científicos daneses consiguió establecer que, alternando entre ciertos pares exactos de antibióticos, es posible evitar la aparición de resistencia en las bacterias. Su estudio se basa en el concepto de «sensibilidad colateral», según el cual el proceso de adaptación de las bacterias para resistir a un antibiótico genera siempre una hipersensibilidad a otro antibiótico. No a cualquier otro, sino a uno concreto de una lista de 23, o, a lo sumo, a unos pocos de esa lista. Los autores creen que su estrategia de ciclos de «sensibilidad colateral» puede ser aplicada al tratamiento de la tuberculosis, a los paliativos de la malaria o a la quimioterapia frente al cáncer.
Se han hecho ensayos in vitro con E. coli y técnicas de evolución artificial para hacerlos resistentes a cada uno de los 23 antibióticos más utilizados en la práctica médica. Ahora deben realizarse ensayos clínicos que demuestren su seguridad y eficacia para poder llevarlos a la práctica clínica.